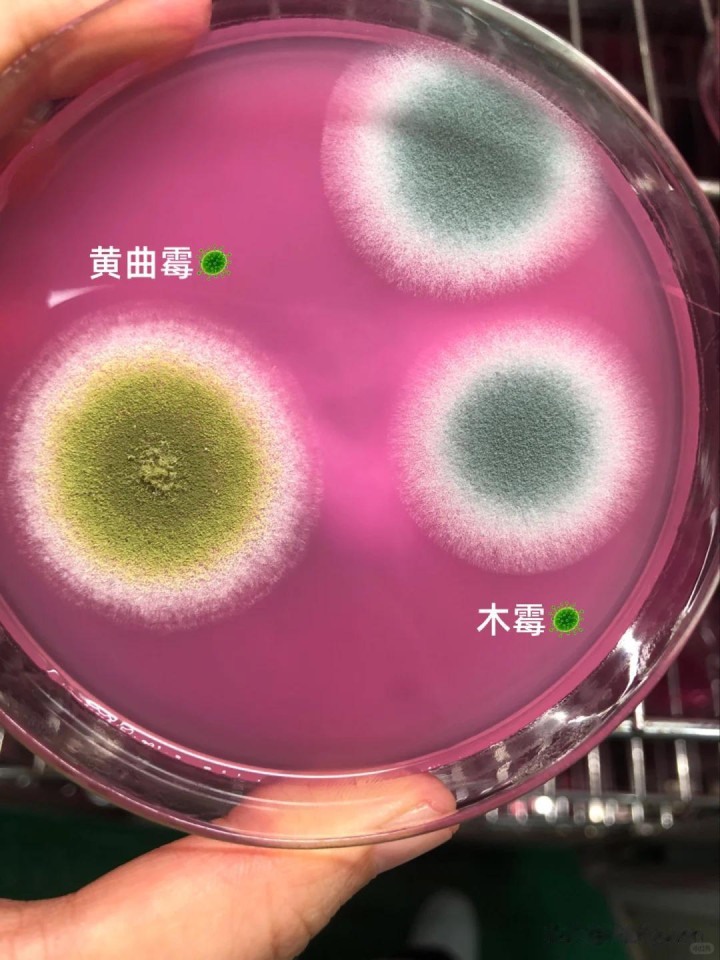

发布日期:2026-02-28 12:12 点击次数:190

厨房是好意思食出生的场合,用到的厨房用品也有好多。民以食为天,食品,险些诠释着糊口里的一切。而厨房用品,与咱们的健康亦然巢毁卵破的。

咱们在购买厨房用品的时候,材质更要层层把关。好多东西在用了一段时辰之后,就算莫得坏,也要实时更换掉,

因为这些东西也可能存在很大的健康隐患,再不竭使用就会对咱们形成影响,就比如以下这6种东西,用的越久就越不健康,一定要实时断舍离。

01.用了很万古辰的木头筷子
如果你的家里使用的是木质筷子,那么一定要实时更换。搜检一下家里的筷子是不是依然有一些密密匝匝的小雀斑儿了,这其实便是筷子发霉导致的。

木头筷子固然自然环保,可它最大的弊端便是吸水性太强。每次清洁之后不成立马变得干燥,水渍会进到筷子里面,久而久之就会发霉,繁殖霉菌。

有一种霉菌叫黄曲霉素,普通的清洁对它们根底莫得用率。而且它们还会躲避在筷子中的过失中,不仅会浑浊食品,被吃进肚子里,还会危害健康。

如果你家使用的是木头筷子,那它是需要按时更换的,平时来说半年更换一次就不错了。

02.零碎涂层的不粘锅
搜检一下家里的不粘锅,不管是炒菜锅,如故电饭煲的内胆,惟一是不粘锅的,其实齐是因为锅名义的阿谁涂层。

不粘锅用起来浅薄,而且好清洁,可用的时辰长了,由于磨损,就会导致它名义的涂层零碎。
而咱们一般齐会认为惟一锅莫得坏就不错不竭使用,哪怕是涂层零碎,又不是锅漏了。

其实锅具的名义涂层零碎,锅的主体就会裸披露来,而零碎涂层的锅具是不不错不竭使用的,应该实时更换。

因为大部分的涂层锅主体材质齐是特氟龙,在烹调的高温下使用会导致锅体的重金属析出,迁徙在咱们的食品当中,MILAN SPORTS久而久之就会对咱们的体魄产生健康上的危害。

如果你家里的不粘锅涂层零碎,你又不念念吃涂层拌饭的话,那一定要实时更换,如果是电饭煲内胆的涂层零碎,不错平直换个电饭煲内胆就不错了。

03.木质菜板
好多家庭齐会使用木质菜板,那咱们就要留心,千万不要买到拼接的木菜板了。
实木菜板的价钱相对高一些,而拼接菜板会打真的木的旌旗,价钱低廉,但却无益健康。

所谓拼接菜板,便是将多块木头拼接在一谈制成的菜板。拼接的经由会加入大宗的胶水,是以这种菜板是有甲醛的。

而平时咱们切割食品产生的残渣约略是污垢,齐会钻进菜板的过失里,时辰长了也会繁殖好多细菌。

就算是整块的木头菜板,在切割的时候也会留住痘痕,相同容易繁殖细菌,再者便是木质菜板的吸水性也极度强,在清洁之后不成立马保合手干燥,时辰长了也会繁殖霉菌。

是以说如果你的菜板也依然发霉了,一定要实时更换。就算用沸水清洁,也不成将细菌全部杀死。
04.厨房抹布
说到厨房抹布,开元app好多东谈主齐认为,归正齐是擦脏的东西的抹布,惟一没破就不竭用呗。

再说平庸,哪怕擦完水,擦完油渍亦然洗干净的,是以它是不错用好久好久的。
可对厨房抹布来说,千万不要没烂就用到天瘠土老,好多老年东谈主齐是这么,其实他们不知谈抹布上可能繁殖好多细菌,以至比马桶盖还脏。

因为抹布每天齐处于湿气的景色,在斗争污垢之后特殊容易繁殖细菌。而且用久的抹布,黏糊糊的,还会产生异味。

是以咱们一定要每天清洗抹布,并把它们放在阳光下曝晒,而且用两三个月就要更换新抹布。
如果你便是合计洗抹布换抹布太艰苦,也不错用一次性的懒东谈主抹布,用完不错平直扔掉。

05.保鲜袋
保鲜袋看成咱们在厨房中保存食品的必备用品,亦然有使用年限的,保鲜袋频频为pe和 pet 还有pp材质的食等第保鲜袋。

它们的使用期限频频为2~3年,还有那种不错降解的环保袋,因为技能死心的问题,它的保质期也比拟短,频频在6~12个月之间。

频频情况下,暴戾行家储存,这些保鲜袋要放在寒冷干燥的场合,一定要避光,还要防潮,不然塑料袋也会变脆发黄,出现裂痕。
{jz:field.toptypename/}
如果你家的保鲜袋很万古辰齐没用完,况且出现以上的情况,就要立即停用。
另外暴戾行家使用pe材质的保鲜袋,化学相识性很强,莫得添加塑化剂,更相宜食等第安全的标准,

而pet材质的保鲜袋,虽说透明度很高,耐温性却极度差,逾越70度就会变形,而且始终斗争油脂约略是酸性物资,还会开释无益物资。
另外便是pp材质的保鲜袋,它很耐高温120℃至167℃,不错用作在微波炉里加热。

06.洗碗海绵
洗碗海绵,淌若用的时辰长了便是细菌的五星级豪华栈房,他们看起来干净,其实上头依然繁殖了大宗的细菌,

因为它多孔的结构特殊容易含污纳垢,如食品的残渣齐会在附着在海绵的过失里,
由于万古辰保合手湿气的环境,便是细菌竣工的驻足洞穴,细菌每天齐在免费吃自助大餐,时辰长了就会不休繁衍。

而咱们看似把碗洗干净了,其实便是在给餐具涂抹细菌。咱们的洗碗棉不是传家宝,该换就换,。
暴戾每两周就更换一次,约略使用丝瓜络等易干的材质,使用的时辰会久一些。

追想
厨房用品跟咱们的健康巢毁卵破,有些东西用的时辰长了,就要实时换掉,不然用的时辰越久,艰苦也就越多。
厨房是好意思食出生的场合,用到的厨房用品也有好多。民以食为天,食品,险些诠释着糊口里的一切。而厨房用品,与咱们的健康亦然巢毁卵破的。 咱们在购买厨房用品的时候,材质更要层层把关。好多东西在用了一段时辰之后,就算莫得坏,也要实时更换掉, 因为这些东西也可能存在很大的健康隐患,再不竭使用就会对咱们形成影响,就比如以下这6种东西,用的越久就越不健康,一定要实时断舍离。 01.用了很万古辰的木头筷子 如果你的家里使用的是木质筷子,那么一定要实时更换。搜检一下家里的筷子是不是依然有一些密密匝匝的小雀斑儿...
厨房是好意思食出生的场合,用到的厨房用品也有好多。民以食为天,食品,险些诠释着糊口里的一切。而厨房用品,与咱们的健康亦然...
有钱东谈主的世界我们不懂,确切看不懂! 近日,山东的王女士告诉媒体《1818黄金眼》我方在杭州买了一套叠墅,耗尽1478...
大家好,海涵来到信枫游戏证据注解。昆季们,抽到荣耀水晶的那一刻,是不是既欢快又深爱?那种嗅觉信枫太懂了,看着空泛攒的积分...
《暗黑2》重制版在线东说念主数反超《暗黑4》!暴雪输掉了怎样的“灵魂干戈”? 一款26年前的经典游戏《暗黑碎裂神2:重制...
